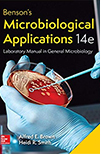

Rehabilitación
Física
qui officia deserunt mollit anim id est laborum. sed ut per
spiciatis unde omnis natus error.
Rehabilitación
Cardíaca
qui officia deserunt mollit anim id est laborum. sed ut per
spiciatis unde omnis natus error.
Projects Completed

Immunology: T-cell tweaks to target tumours

Molecular biology: RNA editing packs a two punch

Cardiovascular disease: Commonality with cancer

Immunology: T-cell tweaks to target tumours
Our Services
- Chrinic Disease
- Cancer Biology
- Atherosclerosis
- Phonetics & Audiology
- Experimental Transplantation

Excepteur sint occaecat cupidatat non proident sunt in culpa qui officia desunt mollit anim id est laborum. sed ut per spiciatis unde omnis natus error vitae Inventore veritatis quasi architebeatae vitae dicta sunt explicabo nemo enim ipsam voluptatem quia voluptassit.aspernatur aut odit aut fugit sed quia eos consequntur magni dolores eos qui ratione
Sequi nesciunt neque porro qusquam est qui dolore ipsum quia dolor sit amet consecteturadipisc velit sed quia non numquam eius modi.

Excepteur sint occaecat cupidatat non proident sunt in culpa qui officia desunt mollit anim id est laborum. sed ut per spiciatis unde omnis natus error vitae Inventore veritatis quasi architebeatae vitae dicta sunt explicabo nemo enim ipsam voluptatem quia voluptassit.aspernatur aut odit aut fugit sed quia eos consequntur magni dolores eos qui ratione
Sequi nesciunt neque porro qusquam est qui dolore ipsum quia dolor sit amet consecteturadipisc velit sed quia non numquam eius modi.

Excepteur sint occaecat cupidatat non proident sunt in culpa qui officia desunt mollit anim id est laborum. sed ut per spiciatis unde omnis natus error vitae Inventore veritatis quasi architebeatae vitae dicta sunt explicabo nemo enim ipsam voluptatem quia voluptassit.aspernatur aut odit aut fugit sed quia eos consequntur magni dolores eos qui ratione
Sequi nesciunt neque porro qusquam est qui dolore ipsum quia dolor sit amet consecteturadipisc velit sed quia non numquam eius modi.

Excepteur sint occaecat cupidatat non proident sunt in culpa qui officia desunt mollit anim id est laborum. sed ut per spiciatis unde omnis natus error vitae Inventore veritatis quasi architebeatae vitae dicta sunt explicabo nemo enim ipsam voluptatem quia voluptassit.aspernatur aut odit aut fugit sed quia eos consequntur magni dolores eos qui ratione
Sequi nesciunt neque porro qusquam est qui dolore ipsum quia dolor sit amet consecteturadipisc velit sed quia non numquam eius modi.
Excepteur sint occaecat cupidatat non proident sunt in culpa qui officia desunt mollit anim id est laborum. sed ut per spiciatis unde omnis natus error vitae Inventore veritatis quasi architebeatae vitae dicta sunt explicabo nemo enim ipsam voluptatem quia voluptassit.aspernatur aut odit aut fugit sed quia eos consequntur magni dolores eos qui ratione
Sequi nesciunt neque porro qusquam est qui dolore ipsum quia dolor sit amet consecteturadipisc velit sed quia non numquam eius modi.
Immunology
Excepteur sint ocecat cupidatatnon proi dent sunt in culpa quiofficia deserunt mollit anim est.
Molecular biology
Excepteur sint ocecat cupidatatnon proi dent sunt in culpa quiofficia deserunt mollit anim est.
Cardiovascular disease
Excepteur sint ocecat cupidatatnon proi dent sunt in culpa quiofficia deserunt mollit anim est.
Heart disease
Excepteur sint ocecat cupidatatnon proi dent sunt in culpa quiofficia deserunt mollit anim est.
Alternative medicine
Excepteur sint ocecat cupidatatnon proi dent sunt in culpa quiofficia deserunt mollit anim est.
Cancer disease
Excepteur sint ocecat cupidatatnon proi dent sunt in culpa quiofficia deserunt mollit anim est.
Immunology: T-cell tweaks
to target tumours
- Bachelor of Science
- Doctor of Philosophy
- Master of Science
- Bachelor of Science
- Doctor of Philosophy
- Master of Science
- Bachelor of Science
- Doctor of Philosophy
- Master of Science
- Bachelor of Science
- Doctor of Philosophy
- Master of Science
Reliable & High
Quality Laboratory
Excepteur sint occaecat cupidatat non proident sunt culpa qui officia deserunt mollit anim id est laborum. sed spiciatis unde omnis natus error Inventore.
quasi architebeatae vitae dicta sunt explicabo nemo enim ipsam volupt atem quia voluptassit. aspernatur aut odit fugit sed quia conse quuntur magni dolores eos qui ratione voluptam sequi nescuntneque porro quisquam dolorem ipsum quia dolor sit amet consectur adipiscing velit sed quia numquam eius modi tempora incidunt ut labore et dolore consectetur adipisicing elit.



Aculia Journal
Lacinia eget consecte sed convallis.
Quasi architebeatae vitae dicta sunt explicabo nemo enim ipsam volupatem quia voluptassit asper natur aut ...
Haematopoietic stem cell transplant.
Quasi architebeatae vitae dicta sunt explicabo nemo enim ipsam volupatem quia voluptassit asper natur aut ...
Excepteur sint occaecat cupidatat.
Quasi architebeatae vitae dicta sunt explicabo nemo enim ipsam volupatem quia voluptassit asper natur aut ...

Lorem ipsum dolor amet constetur adipisicing elit sed eiusm tempor dunt labore dolore magna aliqua enim ad minim veniam.
Contact Us
20700 Maureen Cliffs Suite 654 North Wilbertland, AB G4Y-7A2
Call: +57 2651 2658 3659
Email: example@gmail.com




